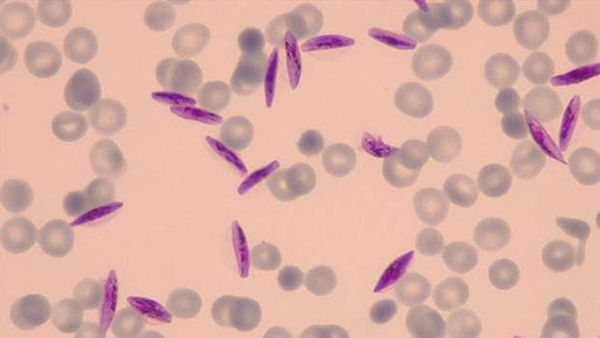

Gametocitos de ‘Plasmodium falciparum’ en eritrocitos humanos - SWISS TPH
Basilea, Suiza, 16/03/2018(El Pueblo en Línea) - La malaria o ‘paludismo’ es una enfermedad causada por parásitos de la familia ‘Plasmodium’ que se transmiten a través de la picadura de mosquitos del género ‘Anopheles’. Una enfermedad infecciosa que, lejos de pertenecer al pasado –los primeros casos diagnosticados datan de hace unos 5.000 a?os–, se corresponde con una de las principales causas de mortalidad global. De hecho, y según los datos de la Organización Mundial de la Salud (OMS), tan solo en el a?o 2016 se registraron cerca de 216 millones de casos y 445.000 decesos por malaria en un total de 91 países. De ahí la importancia, vital, de contar con nuevos fármacos eficaces frente a esta devastadora enfermedad. Y con urgencia. Y en este contexto, investigadores del Instituto Suizo de Salud Pública y Tropical en Basilea (Suiza) parecen haber encontrado la clave para frenar, por fin, la transmisión de la malaria: la inhibición de la proteína GDV1 del parásito, indispensable para la producción de los gametocitos de los plasmodios, según ABC.
Como explica Till Voss, director de esta investigación publicada en la revista ?Science?, ?si bien nuestro trabajo no ofrece una solución inmediata para el desarrollo de terapias innovadoras, arroja una nueva luz sobre los mecanismos responsables de la producción de gametocitos. Y si podemos bloquear estos mecanismos o eliminar todos los gametocitos, entonces daremos un paso muy importante para interrumpir la transmisión de la infección?.
Como refiere Michael Filarsky, co-autor de la investigación, ?nos asombró ver que tras interrumpir de forma dirigida esta molécula inhibitoria con el uso de la tecnología de edición genética CRISPR/Cas9, todos los parásitos expresaron la proteína GDV1. Además, también observamos que la producción de GDV1 se inhibe en la presencia de LPC. Por tanto, nuestros resultados muestran la vía molecular que transporta un estímulo ambiental en el parásito para activar el desarrollo de gametocitos?.
En definitiva, el estudio identifica el mecanismo por el que los parásitos se transforman en gametocitos para perpetuar la infección. Así, el próximo paso será hallar la manera para bloquear este mecanismo y evitar que los gametocitos lleguen a los mosquitos. Y es que erradicada la malaria en los insectos transmisores, también se erradicará la enfermedad en los humanos.
Sillitas para esperar el autobús,
la última invención en una economía compartida
Se filtra por error el sexto episodio
de ?Juego de Tronos?
Un robot monje aprende a hablar inglés
Se estrena el documental
sobre “mujeres de consuelo” de China
57 universidades chinas
entre las 500 mejores del mundo
Las 10 cadenas hoteleras
más grandes del mundo
?Cuánto paga un residente extranjero
por un alquiler en Beijing?
Un graduado de Tsinghua convierte
la cría del esturión cuchara en una mina de oro
La dedicación de una ni?a
al arte de la ópera de Pekín


